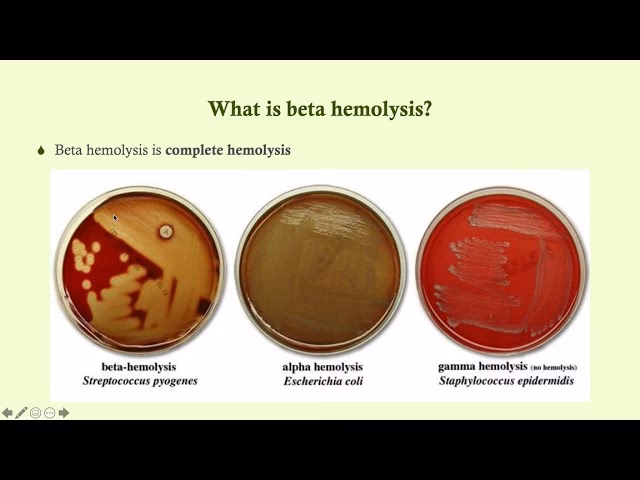
Are beta-hemolytic streptococci zoonotic?

10/11/2014
Beta-hæmolytiske streptokokker er en type grampositive bakterier, der er ansvarlige for en række infektioner hos mennesker, primært i halsen og på huden. Mens nogle stammer forårsager milde gener, kan andre være yderst farlige og føre til livstruende tilstande. At forstå det grundlæggende om disse bakterier er afgørende for både sundhedspersonale og den generelle befolkning. Viden muliggør hurtig forebyggelse og effektiv behandling af infektioner. Ved at genkende de tidlige tegn og søge lægehjælp rettidigt kan man markant reducere risikoen for alvorlige komplikationer.
For at forstå disse bakterier fuldt ud, er det nyttigt at nedbryde deres navn. 'Streptokokker' kommer fra græsk og betyder 'snoet bær', hvilket beskriver deres udseende under et mikroskop, hvor de ofte ses i kæder eller par. Udtrykket 'hæmolytisk' refererer til deres evne til at nedbryde røde blodlegemer (hæmolyse). 'Beta' specificerer typen af hæmolyse. Når beta-hæmolytiske streptokokker dyrkes på en blodagarplade i et laboratorium, skaber de en fuldstændig nedbrydning af de røde blodlegemer omkring deres kolonier. Dette resulterer i en klar, gennemsigtig zone, som gør det let for mikrobiologer at identificere dem og skelne dem fra andre typer streptokokker, såsom alfa-hæmolytiske (delvis nedbrydning) og gamma-hæmolytiske (ingen nedbrydning).
Kategorier af Streptokokker: Gruppe A og Gruppe B i Fokus
Beta-hæmolytiske streptokokker klassificeres yderligere i forskellige grupper baseret på specifikke kulhydratantigener på deres cellevæg, et system udviklet af Rebecca Lancefield. De mest klinisk signifikante for mennesker er Gruppe A og Gruppe B.
Gruppe A Streptokokker (GAS)
Også kendt som Streptococcus pyogenes, er gruppe A streptokokker årsagen til mange almindelige infektioner. Den mest kendte er streptokok-halsbetændelse (faryngitis), som er karakteriseret ved en meget smertefuld hals, feber og hævede mandler. Andre hudinfektioner som børnesår (impetigo) og rosen (erysipelas) er også almindelige. Selvom disse infektioner ofte er milde, kan GAS føre til alvorlige og invasive sygdomme, herunder:
- Skarlagensfeber: En sygdom, der oftest rammer børn og forårsager et karakteristisk rødt udslæt, feber og 'jordbærtunge'.
- Nekrotiserende fasciitis: En sjælden, men ekstremt alvorlig infektion, der ødelægger hud, fedt og muskelvæv. Den er berygtet som den 'kødædende bakterie'.
- Streptokok Toksisk Shock Syndrom (STSS): En hurtigt progredierende, livstruende tilstand, der forårsager organsvigt.
- Gigtfeber: En inflammatorisk sygdom, der kan udvikle sig efter en ubehandlet halsbetændelse og påvirke hjerte, led, hjerne og hud.
Gruppe B Streptokokker (GBS)
Streptococcus agalactiae, eller Gruppe B Streptokokker, findes typisk i mave-tarmkanalen og de nedre kønsorganer hos op til 30% af alle raske voksne uden at forårsage symptomer. De udgør dog en betydelig risiko for specifikke befolkningsgrupper. GBS er den førende årsag til alvorlige infektioner hos nyfødte, herunder lungebetændelse, blodforgiftning (sepsis) og meningitis. Spædbørn kan blive smittet under fødslen, hvis moderen er bærer af bakterien. Derfor screenes gravide kvinder ofte for GBS. Ældre voksne og personer med svækket immunforsvar er også sårbare over for GBS-infektioner, som kan forårsage lungebetændelse, urinvejsinfektioner og infektioner i blodet.

Hvordan Smittes Man med Beta-hæmolytiske Streptokokker?
Smittevejen afhænger af typen af streptokok. Gruppe A streptokokker er meget smitsomme og spredes primært gennem luftbårne dråber, når en smittet person hoster eller nyser. Man kan også blive smittet ved direkte kontakt med inficerede sår på huden. Tæt kontakt i miljøer som skoler, børnehaver og kaserner øger risikoen for udbrud markant.
Forståelse af smittespredning er nøglen til forebyggelse. God håndhygiejne er den mest effektive metode til at forhindre spredning.
Typiske Smittemiljøer og Forebyggelse
| Miljø | Smitterisiko | Forebyggende Foranstaltninger |
|---|---|---|
| Skoler | Høj | Hyppig håndvask, hoste/nyse i ærmet, blive hjemme ved sygdom. |
| Daginstitutioner | Høj | Regelmæssig rengøring af overflader og legetøj, god håndhygiejne hos børn og personale. |
| Offentlig Transport | Moderat | Brug af håndsprit, undgå at røre ved ansigtet. |
| Husholdninger | Variabel | Isolering af den syge person, hyppig rengøring af fælles berøringsflader. |
Symptomer på en Streptokokinfektion
At kunne genkende symptomerne er afgørende for at søge behandling i tide og forhindre komplikationer.
Typiske Symptomer på Halsbetændelse
En klassisk halsbetændelse forårsaget af Gruppe A streptokokker viser sig ofte ved:
- Pludselig og kraftig ondt i halsen
- Smerter ved synkning
- Feber (ofte over 38,3°C)
- Hævede og røde mandler, nogle gange med hvide pletter eller pus
- Hævede lymfeknuder på halsen
- Hovedpine og muskelsmerter
- Kvalme eller opkastning, især hos yngre børn
Alvorlige Advarselssignaler
Selvom det er sjældent, kan infektionen blive alvorlig. Søg omgående lægehjælp, hvis du eller dit barn oplever:
- Høj feber ledsaget af et fint, sandpapir-lignende udslæt (tegn på skarlagensfeber)
- Åndedrætsbesvær
- Ekstrem smerte, hævelse og rødme på et specifikt område af huden, der spreder sig hurtigt (tegn på nekrotiserende fasciitis)
- Forvirring, svimmelhed eller lavt blodtryk (tegn på STSS)
- Mørk, rustfarvet urin eller nedsat urinproduktion (tegn på nyrepåvirkning)
Diagnose og Behandling
En præcis diagnose er nødvendig, da symptomerne på streptokok-halsbetændelse kan ligne dem fra en virusinfektion, hvor antibiotika er virkningsløse.

Sådan Stilles Diagnosen
Lægen vil typisk foretage en hurtigtest, også kendt som en Strep A-test. Dette involverer en podning fra halsen, og resultatet er klar inden for få minutter. Hvis testen er positiv, kan behandling påbegyndes med det samme. Hvis den er negativ, men mistanken stadig er stærk, kan lægen sende en podning til dyrkning i et laboratorium. Dette tager et par dage, men er mere præcist.
Behandlingsstrategier
Den primære behandling for bakterielle streptokokinfektioner er antibiotika. Penicillin er typisk førstevalget på grund af dets effektivitet og lave omkostninger. For patienter med penicillinallergi findes der alternativer som erythromycin eller azithromycin. Det er ekstremt vigtigt at fuldføre hele antibiotikakuren, selvom man føler sig bedre tilpas efter få dage. Dette sikrer, at alle bakterier er elimineret og reducerer risikoen for komplikationer og antibiotikaresistens.
Udover antibiotika kan symptomer lindres med smertestillende medicin som paracetamol eller ibuprofen, hvile og rigelig væskeindtagelse.
| Antibiotika Type | Anvendelse | Almindelige Alternativer |
|---|---|---|
| Penicillin | Førstevalgsbehandling for de fleste streptokokinfektioner. | Amoxicillin |
| Erythromycin | Anvendes ved penicillinallergi. | Clindamycin |
| Azithromycin | Alternativ ved penicillinallergi, ofte med en kortere behandlingsvarighed. | Clarithromycin |
Ofte Stillede Spørgsmål
Er beta-hæmolytiske streptokokker altid farlige?
Nej, ikke altid. Mange mennesker bærer Gruppe B streptokokker uden symptomer. Infektioner med Gruppe A streptokokker som halsbetændelse er almindelige og normalt ikke farlige, når de behandles korrekt med antibiotika. Faren opstår, når infektioner efterlades ubehandlede eller når bakterien bliver invasiv og spreder sig til dele af kroppen, hvor den normalt ikke findes, som f.eks. blodet eller musklerne.

Hvor hurtigt virker antibiotika mod halsbetændelse?
De fleste vil opleve en markant forbedring af deres symptomer inden for 24 til 48 timer efter påbegyndt antibiotikabehandling. Feberen falder, og halssmerterne aftager. Man betragtes typisk som smittefri efter 24 timers behandling. Det er dog afgørende at fuldføre hele kuren for at forhindre tilbagefald og alvorlige komplikationer.
Kan man få streptokokker mere end én gang?
Ja, det er desværre muligt at få streptokokinfektioner, især halsbetændelse, flere gange. Der findes mange forskellige stammer af Gruppe A streptokokker, og immunitet over for én stamme beskytter ikke nødvendigvis mod andre. Tæt kontakt i skoler og børnehaver gør, at børn er særligt udsatte for gentagne infektioner.
Hvad er forskellen på beta-, alfa- og gamma-hæmolyse?
Dette er en laboratorieteknisk klassifikation baseret på, hvordan bakterierne påvirker røde blodlegemer på en agarplade. Beta-hæmolyse (f.eks. S. pyogenes) er en fuldstændig nedbrydning, der skaber en klar zone. Alfa-hæmolyse (f.eks. S. pneumoniae) er en delvis nedbrydning, der skaber en grønlig zone. Gamma-hæmolyse (f.eks. Enterococcus faecalis) betyder, at der slet ingen nedbrydning sker.
Hvis du vil læse andre artikler, der ligner Forstå Beta-hæmolytiske Streptokokker, kan du besøge kategorien Sundhed.
